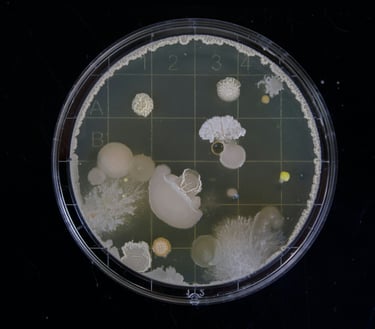
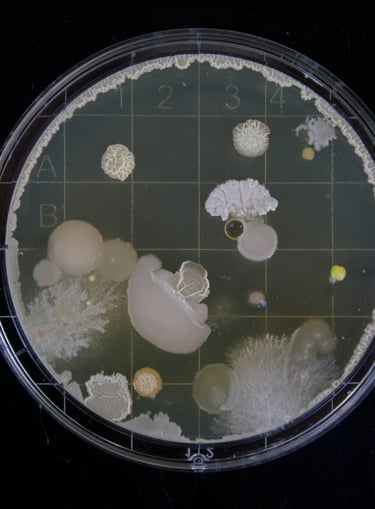

Multiomics research focused on investigating:
> Host-Pathogen Interaction
> Antimicrobial Resistance
> Microbial Interaction
Decoding microbes, Revealing mechanisms
Design experiments. Generate data. Integrate analyses.


We operate globally
Multiomics Integration
Tailored Modules
Advanced Bioinformatics
Project Development
Scientific Collaboration
RESEARCH FOCUS
Host-Pathogen Interaction
We investigate how microbes interact with their hosts and with each other, uncover pathways that define infection outcomes and microbial balance. We create omics workflows to elucidate host-pathogen crosstalk, decipher immune evasion mechanisms and elucidate the pathogenesis of infectious organisms.


Immune Response
We design integrated multiomics pipelines to dissect host immune responses and uncover strategies of immune evasion employed by pathogens. Our approaches enable comprehensive characterization of immune repertoires across multiple experimental contexts.


Antimicrobial Resistance (AMR)
We apply experimental pipelines to elucidate drug resistance mechanisms and identify drug targets through integrated omics analysis. Scrutinize drug response, mechanism of action and preclinical development using our integrated multiomics framework.

Applied Microbiology
Translate complex biological data into practical applications across health, agriculture, and environment. We can generate systems-level insights to identify infection biomarker or diagnostic signatures, decipher crop-microbe interaction and profile microbial communities in soil, water, food, and industrial ecosystems.


Microbiology
We explore microorganisms across the full microbial spectrum — from bacteria and fungi to protozoa and viruses — using integrated omics approaches. We collaborate to develop and implement omics strategies to scrutinize molecular biology of organisms, virulence mechanisms, microbial adaptation and evolution.


Cooperations

Collaboration opportunities.
For further discussion or to schedule a meeting, please contact us. You may also write us at info@genomebyte.com


About GenomeByte
GenomeByte is an integrated research and discovery platform operating at the intersection of microbiology, data science, and applied biotechnology. Rooted in academic collaboration and open reproducible research, the platform embeds a wide spectrum of customisable multiomics workflows, encompassing tailored experimental strategies and bioinformatics applications. The primary goal is to advance fundamental and translational understanding in microbial genomics, infection biology, host–pathogen interactions, antimicrobial resistance, and applied microbiology.



